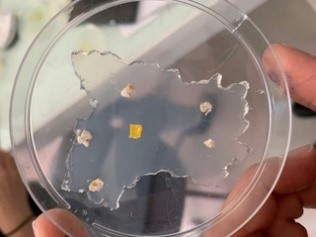

Le lycée de la Découverte élève son BLOB
Le projet
A Decazeville en Aveyron nous nous sommes engagés comme 4500 autres établissements dans l’expérience éducative originale : #EleveTonBlob.
Dotés de notre Blob LU352 (souche identique à celle envoyée dans l’ISS) nous avons mené dans l’établissement la même expérience que celle menée en micropesanteur par Thomas Pesquet. Cette expérimentation hors du commun et inédite, nous a amené à la Cité de l’espace de Toulouse pour poser nos questions à Thomas Pesquet en direct depuis la station spatiale internationale.
Après une très longue préparation technique (pour la prise de vue des expérimentations), nous avons mis en œuvre les protocoles scientifiques donnés par Mme Dussutour Audrey (Directrice de recherche sur la cognition animale au CNRS (Centre National de Recherche Scientifique)) avant d’avoir la chance d’observer les déplacements de notre Blob et pouvoir les comparer aux enregistrements réalisés dans l’ISS.
L’expérimentation
Une expérience par laquelle nous avons beaucoup appris !
• La démarche expérimentale et la rigueur nécessaire à la mise en œuvre des expériences.
• La persévérance, ne pas se décourager, surmonter les problèmes techniques, recommencer encore et encore afin d’arriver à un résultat satisfaisant.
• L’autonomie et l’esprit d’équipe, responsables de nos Blobs, nous avons appris à les maintenir en vie, les mettre en sclérotes, concevoir et réaliser nos expériences…et faire la vaisselle !
• La créativité, nous nous sommes inspirés d’expérimentations présentées par Mme Dussutour, nous les avons modifiées pour élargir et aller plus loin dans l’exploration.
De notre curiosité, de nos observations partagées sont nées de nouvelles idées à mettre en place.

Une expérience joyeuse et sérieuse c’est possible !
Même en restant rigoureux et en comprenant l’importance de cette expérience éducative, nous avons apprécié le côté ludique du travail mené auprès de nos Blobs et le fait d’obtenir des résultats exploitables rapidement. »
Ce fut une expérience vraiment INCROYABLE, à la fois par l’observation du Blob un être aux capacités étonnantes, la rencontre avec la communauté des chercheurs et scientifiques et par le lien avec des sujets d’études actuels sur le changement climatique et la biodiversité.
Une expérience « Vers l’infini et au-delà », puisque nous avons également pu approcher le monde du spatial à travers une visioconférence en direct de l’ISS avec Thomas Pesquet depuis la cité de l’Espace grâce aux moyens et équipes techniques du domaine spatial.
Une expérience collaborative.
Merci au CNES, au CNRS, à Thomas Pesquet, à la cité de l’Espace et surtout à l’ensemble de l’équipe pédagogique du lycée de la Découverte de nous avoir permis de découvrir plus concrètement l’intérêt, les perspectives et les possibilités du monde de la Recherche et du Spatial.
BONUS
Tour de France 2022 de notre Blob en maillot ![]()

En savoir plus : Expérience Blob dans l’ISS